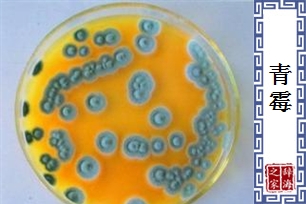
青霉

【青霉】是什么意思
- 一种微生物。麴菌科青霉属。寄生于糕饼、面包、浆糊、肉类、皮革、蔬果等有机物上,生长菌丝,菌丝上挺生细长的柄,柄端生球形孢子,成熟时呈青、绿色。所分泌的青霉素,可以抑制细菌生长,提炼抗生素。
【青霉】 图片鉴赏
相关词语
查字典的部份资料来自网络或由网友提供,不保留版权,如有侵权,请与我们联系以从站上删除! 免责声明:本站非营利性站点,以方便网友为主,仅供学习。
Tip:SCCG
